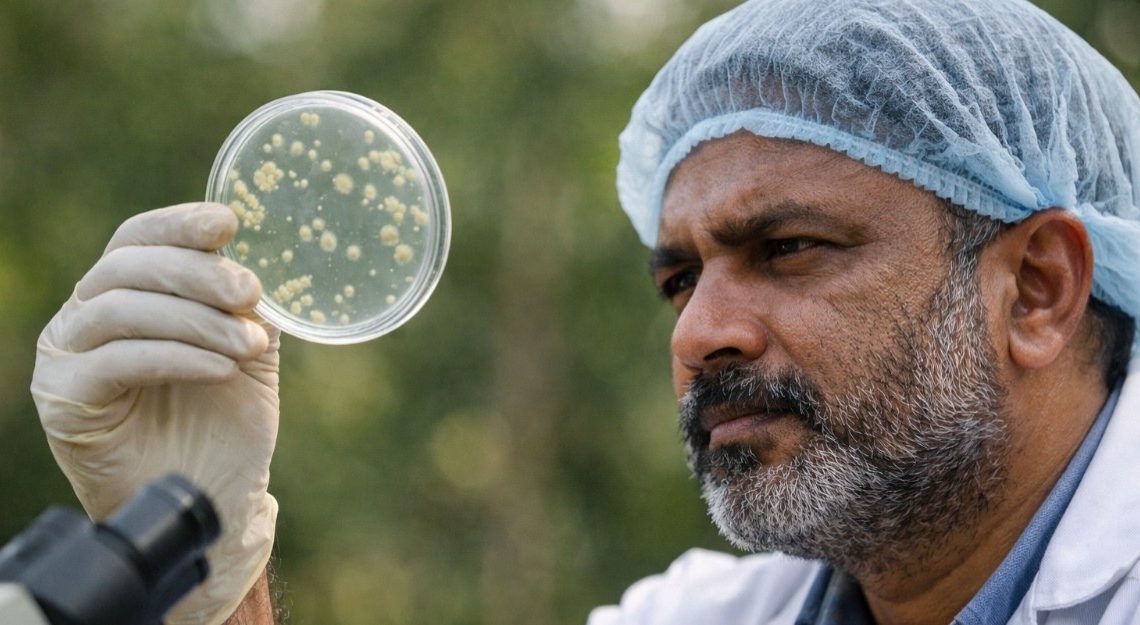

కేరళ అడవులు, నదులు, పచ్చదనం మాత్రమే కాదు.. ఆ నేలలో దాగి ఉన్న కంటికి కనపడని జీవి కూడా ఇప్పుడు మాట్లాడుతోంది. పక్షులు, జంతువులు, పూల తర్వాత.. ఒక బ్యాక్టీరియాను రాష్ట్ర సూక్ష్మజీవిగా అక్కడి ప్రభుత్వం ప్రకటించడం తీవ్ర చర్చకు దారితీసింది. పేరు వినగానే చాలామందికి భయం కలిగించే బ్యాక్టీరియా ఒక రాష్ట్రానికి ప్రతీకగా మారడమంటే సాధారణ విషయమేమీ కాదు. ఈ బ్యాక్టీరియా మన నేలలో ఉంటుంది. మన పేగుల్లో ఉంటుంది. మొక్కలకు బలాన్ని ఇస్తుంది. శరీరానికి రక్షణగా నిలుస్తుంది. అదే బ్యాసిలస్ సబిలస్.
ఈ నిర్ణయం కేవలం గుర్తింపు కాదు. మనం ఇప్పటివరకు భయపడుతూ చూసిన సూక్ష్మజీవుల ప్రపంచాన్ని కొత్త కోణంలో చూడమన్న ఆహ్వానం. మంచి బ్యాక్టీరియా లేకుండా మనిషి, ప్రకృతి రెండూ బతకలేవన్న నిజాన్ని గుర్తుచేసే సంకేతం.
సూక్ష్మజీవులు అంటే వ్యాధులకు కారణమనే భయం మనలో బలంగా ఉంది. కానీ సైన్స్ చెబుతున్న నిజం వేరే. ప్రకృతిలో ఉన్న సూక్ష్మజీవుల్లో హానికరమైనవి ఒక శాతం కూడా ఉండవు. మిగతా ఎక్కువ భాగం మన ఆరోగ్యానికి, పర్యావరణానికి సహకరించే మంచి సూక్ష్మజీవులే ఉంటాయి. కేరళ ప్రభుత్వం తీసుకున్న ఈ నిర్ణయం ఆ భయాన్ని చెరిపేసే ప్రయత్నంగా చూడాలి. బ్యాక్టీరియా అంటే వ్యాధి మాత్రమే కాదన్న అవగాహనను ప్రజల్లోకి తీసుకురావడమే కేరళ ప్రభుత్వ లక్ష్యంగా కనిపిస్తోంది.
కేరళ రాష్ట్ర సూక్ష్మజీవిగా ఎంపికైన బ్యాసిలస్ సబిలస్ నేలలో సహజంగా ఉండే బ్యాక్టీరియా. ఇది మనిషి పేగుల్లో కూడా ఇది సాధారణంగా కనిపిస్తుంది.
ముఖ్యంగా ఇది అత్యంత ప్రతికూల పరిస్థితుల్లోనూ బతికే సామర్థ్యం కలిగి ఉండటం శాస్త్రవేత్తలను ఆశ్చర్యపరిచింది. తీవ్రమైన వేడి, రేడియేషన్, ఆక్సిజన్ లేని పరిస్థితుల్లో కూడా ఇది జీవించగలదు. ఏకంగా అంతరిక్షంలో ఆరేళ్లపాటు జీవించి ఉండడం ద్వారా ప్రపంచ శాస్త్రరంగంలో ప్రత్యేక గుర్తింపు పొందింది. అమెరికా ఉపగ్రహంపై ప్రయోగాత్మకంగా పంపిన ఈ బ్యాక్టీరియా అంత కాలం మనుగడ సాగించడం ఒక రికార్డుగా నిలిచింది.
ఇటు వ్యవసాయ రంగంలో బ్యాసిలస్ సబిలస్ పాత్ర చాలా కీలకం. ఇది మొక్కలకు ప్రో-బయాటిక్లా పనిచేస్తుంది. నేల ఆరోగ్యాన్ని మెరుగుపరుస్తుంది. హానికరమైన శిలీంద్రాలు, బ్యాక్టీరియా నుంచి పంటలను కాపాడుతుంది. మొక్కల వృద్ధిని ప్రోత్సహిస్తుంది. అందుకే బయో ఫెర్టిలైజర్లు, బయో పెస్టిసైడ్ల తయారీలో ఈ సూక్ష్మజీవిని వాడుతున్నారు. రసాయన ఎరువులపై ఆధారాన్ని తగ్గించే పరిష్కారాల్లో ఇది కీలకంగా మారుతోంది. ఇటు మనిషి ఆరోగ్య పరంగా కూడా బ్యాసిలస్ సబిలస్ ఎంతో సురక్షితమని శాస్త్రీయంగా ప్రూవ్ అయ్యింది. ఇది ప్రో-బయాటిక్గా పనిచేసి పేగుల ఆరోగ్యాన్ని మెరుగుపరుస్తుంది. రైబోఫ్లావిన్ లాంటి విటమిన్లు, కొన్ని యాంటీబయాటిక్స్ తయారీలో దీన్ని ఉపయోగిస్తారు. ఇక పులియబెట్టిన ఆహార పదార్థాల్లో సహజంగా ఉండే ఈ సూక్ష్మజీవి మన రోజువారీ ఆహారంలో కూడా భాగమే.
ఇంతకంటే ఆసక్తికరమైన విషయం ఏమిటంటే నిర్మాణ రంగంలో కూడా బ్యాసిలస్ సబిలస్ వినియోగం పెరుగుతోంది. సెల్ఫ్ హీలింగ్ కాంక్రీటులో ఈ బ్యాక్టీరియాను ఉపయోగిస్తారు. భవనాల్లో పగుళ్లు ఏర్పడినప్పుడు, ఇవి క్యాల్షియం కార్బోనేట్ ఉత్పత్తి చేసి ఆ చీలికలను నింపుతాయి. అంటే కాంక్రీటే తనంతట తానే బాగుపడే విధానంలో ఈ సూక్ష్మజీవి పనిచేస్తుంది. మరోవైపు సూక్ష్మజీవుల ఆధారిత పరిశ్రమ భవిష్యత్తులో భారీ అవకాశాలను కలిగి ఉంది. భారత్లో ఫెర్మెంటేషన్ టెక్నాలజీ మార్కెట్ విలువ ఇప్పుడే వేల కోట్లలో ఉంది. 2030 నాటికి అది మరింత వేగంగా పెరుగుతుందని అంచనాలు చెబుతున్నాయి. వైద్య చికిత్సల్లో కూడా వ్యక్తి పేగుల్లోని బ్యాక్టీరియాను విశ్లేషించి చికిత్సలు అందించే మైక్రో-బయోమ్ థెరపీ వేగంగా విస్తరిస్తోంది. మానవ శరీరంలో ఉన్న బ్యాక్టీరియాలో దాదాపు 85 శాతం ప్రయోజనకరమైనవే అనే నిజాన్ని ఇప్పుడు సైన్స్ అంగీకరిస్తోంది.
అందుకే కేరళ తీసుకున్న ఈ నిర్ణయం ఒక రాష్ట్ర ప్రకటనగా మాత్రమే చూడలేం. ఇది మన ఆలోచనల్లో మార్పు తీసుకురావాలన్న ప్రయత్నం. కంటికి కనిపించని జీవి లేకుండా మన జీవితం సాగదన్న సత్యాన్ని గుర్తుచేసే సంకేతం.

Sabarimala: మకరజ్యోతి మర్మం ఏంటి? అసలు సూర్యుడు రాశులు జంప్ చేయడం ఏంటి గురు..!!
Sabarimala: మకరజ్యోతి మర్మం ఏంటి? అసలు సూర్యుడు రాశులు జంప్ చేయడం ఏంటి గురు..!!  Kerala Floods Humanity: పరిఢవిల్లిన మానవత్వం.. కష్టకాలంలో ఐక్యతా రాగం!
Kerala Floods Humanity: పరిఢవిల్లిన మానవత్వం.. కష్టకాలంలో ఐక్యతా రాగం!  Wayand Landslides Death Reason: కొండచరియలు కింద చితికిపోయిన వందల బతుకులు.. కారణం ఇదే!
Wayand Landslides Death Reason: కొండచరియలు కింద చితికిపోయిన వందల బతుకులు.. కారణం ఇదే!  Floods Causes: ఆధునిక దేవాలయాలే మనకు శాపాలా ? వేలాది ప్రాణాలను తీస్తున్న ప్రభుత్వాల నిర్లక్ష్యం..!!
Floods Causes: ఆధునిక దేవాలయాలే మనకు శాపాలా ? వేలాది ప్రాణాలను తీస్తున్న ప్రభుత్వాల నిర్లక్ష్యం..!!  The Real Kerala Story: ప్రగతికి మార్గం చదువే! కేరళ ప్రభుత్వం చెబుతున్న లింగ సమానత్వ పాఠాలు!!
The Real Kerala Story: ప్రగతికి మార్గం చదువే! కేరళ ప్రభుత్వం చెబుతున్న లింగ సమానత్వ పాఠాలు!!  LGBTQ: మరణించిన తర్వాత కూడా వారిపై వివక్షే.. అంతిమసంస్కారాల కోసం ‘గే’ నరకవేదన!
LGBTQ: మరణించిన తర్వాత కూడా వారిపై వివక్షే.. అంతిమసంస్కారాల కోసం ‘గే’ నరకవేదన!